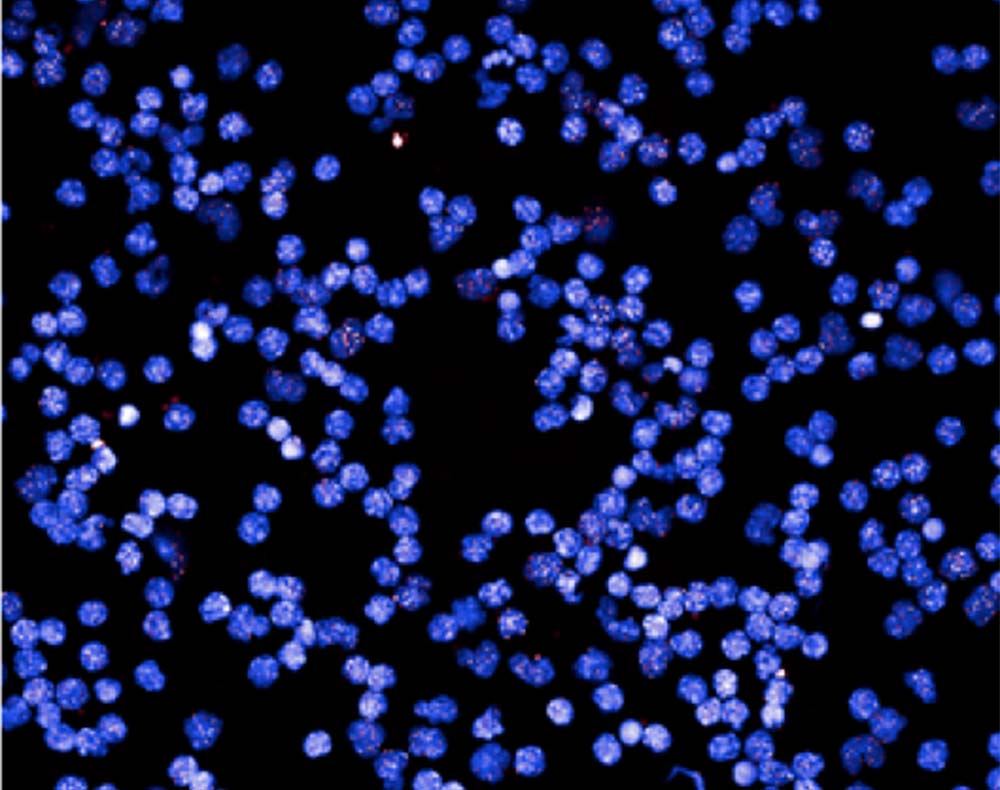

Комплекс СИМїОНИЯ №1 - Сенсация мирового значения!
Степень клеточного старения организма наших постоянных клиентов, более чем на 35 лет моложе их возраста!!!
26 февраля 2026 года получен результат анализа длины Теломер очередного нашего постоянного клиента, который на регулярной основе в течение 3 лет принимал Комплекс СИМїОНИЯ №1.
На момент проведения исследования нашему клиенту было 83 года.
Согласно полученному результату степень клеточного старения организма нашего клиента почти на 40 лет моложе его возраста!
Предлагаем Вам ознакомиться с полным текстом анализа в формате PDF:
2026-02-26.pdf


03 февраля 2023 года получен результат анализа длины Теломер второго человека из наших постоянных клиентов, который в течение 3 лет принимал Комплекс СИМїОНИЯ №1.
Анализ проведён в лаборатории Life Length (Мадрид, Испания) - ведущей лаборатории мира, специализирующейся на анализе длины Теломер.
На момент проведения исследования нашему клиенту было 64 года.
Результат анализа на короткие Теломеры (20-й процентиль, так как это самый важный показатель) показал, что степень клеточного старения организма нашего клиента более чем на 45 лет моложе его возраста!!!
Мы создали для Вас короткую версию самого важного из анализа на русском языке в формате PDF, которую Вы можете посмотреть прямо здесь:
TRLL001008_Russian.pdf
Для получения полного текста анализа в оригинале на английском языке, пожалуйста, обратитесь в нашу компанию, нажав кнопку

25 ноября 2022 года получен результат анализа длины Теломер одного из наших первых клиентов, который в течение 4 лет принимал Комплекс СИМїОНИЯ №1.
Анализ проведён в лаборатории Life Length (Мадрид, Испания) - ведущей лаборатории мира, специализирующейся на анализе длины Теломер.
На момент проведения исследования нашему клиенту было почти 55 лет.
Результат анализа на короткие Теломеры (20-й процентиль, так как это самый важный показатель) означает, что степень клеточного старения организма нашего клиента более чем на 35 лет моложе его возраста, даже не смотря на то, что его стаж курильщика более 38 лет!!!
Мы создали для Вас короткую версию самого важного из анализа на русском языке в формате PDF, которую Вы можете посмотреть прямо здесь:
ESLL008353_Russian.pdf
Для получения полного текста анализа в оригинале на английском языке, пожалуйста, обратитесь в нашу компанию, нажав кнопку

Уникальная комбинация пяти компонентов натурального происхождения

Комплекс СИМїОНИЯ №1 имеет ошеломительный успех!
Наши покупатели потрясены эффектом и продолжают принимать его на постоянной основе. После каждых трёх месячных курсов (12 недель) нужно делать перерыв на 14 дней.
За несколько лет продаж мы получаем только слова благодарности от наших покупателей.
Мы решили систематизировать и кратко изложить только те эффекты, которые наши покупатели описали во многих сотнях отзывов. Вы можете посмотреть все эти отзывы здесь в разделе «Отзывы».
1. Отмеченный покупателями Эффект:
- Возвращение жизненной энергии, молодости.
- Повышается качество сна.
- Лёгкие утренние подъёмы в хорошем настроении несмотря на количество часов сна.
- Значительный рост физической и психоэмоциональной выносливости организма.
- Ослабление чувства лени.
- Появляется желание работать, творить, созидать.
- Часто повышенное настроение и чувство уверенности в завтрашнем дне и, как следствие, отказ от требовавшегося ранее алкоголя для подъёма настроения и соответственно улучшения семейных отношений.
- Уменьшение количества выкуренных сигарет в день с 20-25 штук до 7-10 штук.
- Ощущение состояния душевного покоя: например, перестают срываться на окружающих при ПМС, это приводит к улучшению, атмосферы взаимопонимания в коллективе и в семейных отношениях.
Биологически активные вещества, входящие в состав комплекса омоложения СИМїОНИЯ №1 дают такой мощный синергетический эффект общетонизирующего действия при мягком влиянии на организм.


2. Отмеченный покупателями Эффект:
- Увеличивается скорость мысли, улучшается качество мышления, ускоряется время нахождения правильного решения проблемы.
- Значительно улучшается концентрация внимания, приводящая к карьерному росту.
- Улучшается память: например, покупатель в 80-летнем возрасте перестал забывать закрывать кран после того, как помыл руки.
Действие активных компонентов комплекса по улучшению работы головного мозга широко известно из описаний традиционной китайской медицины.
3. Отмеченный покупателями Эффект:
- Снижается выпадение волос.
- Укрепляются ногти.
- Свежеет цвет лица.
- Уходят прыщики.
Улучшение кровообращения приводит к более активному поступлению питания кислородом и необходимыми микроэлементами в область подкожных тканей лица, волосяных и ногтевых фолликул, тем самым укрепляя их.


4. Отмеченный покупателями Эффект:
- Значительное улучшение стабилизации эрекции у мужчин уже после приёма 6-месячного курса СИМїОНИЯ №1.
1. Под влиянием действия комплекса постепенно происходит очистка тончайших капилляров, находящихся в половом члене, которые с возрастом забиваются и не позволяют в момент эрекции принять тот объём крови, который половой член был способен принимать в молодые годы.
2. 80% проблем с эрекцией у мужчины связано с усталостью и психологическим состоянием. Так как СИМФОНИЯ №1 даёт сильную энергетическую подпитку и значительное повышение настроения, то мужчина меньше чувствует усталость, проходят пустые беспокойства, а тогда у мужчины только одно желание.
5. Отмеченный покупателями Эффект:
- В большинстве случаев полностью избавляет от метеозависимости.
- Нормализуется кровяное давление.
- Пропадают головные боли.
Действие активных компонентов комплекса СИМїОНИЯ №1 по контролю давления широко известно из описаний традиционной китайской медицины.


6. Отмеченный покупателями Эффект:
- Налаживается работа желудочно-кишечного тракта. Исчезают изжога, запоры. И как следствие - пропадают высыпания на лице, прыщи, угри, акне.
Биоактивные компоненты СИМїОНИЯ №1 оказывают воздействие на париетальные клетки, расположенные в стенке желудка.
7. Отмеченный покупателями Эффект:
- Устойчивость к простудным и вирусным заболеваниям даже когда переболела вся семья!
- Легче проходит акклиматизация после перелётов и переездов.
Фармакологически доказано иммуномодулирующее действие ключевых компонентов комплекса СИМїОНИЯ №1.
Повышается иммунитет.


8. Отмеченный покупателями Эффект:
- Снижение массы тела на 1-2 кг в месяц.
1. Нормализацией обмена веществ, ускорением метаболизма, что в свою очередь приводит к более быстрому расщеплению жиров.
2. Действием активных компонентов комплекса на контроль аппетита.
3. Повышение жизненной энергетики приводит к снижению влияния лени на вашу физическую активность и тем самым увеличивается расход калорий.
4. Общее повышение настроения приводит к тому, что вы не заедаете беспокойства.
5. Наши покупатели отмечают существенное увеличение силы воли, что позволяет хотя бы частично ограничить вечерний приём пищи.
И последнее и главное действие препарата СИМїОНИЯ №1, это высокоэффективное снижение степени клеточного старения, то есть Общее Омоложение организма!
Объясняется:
Нейтрализацией свободных радикалов мощными антиоксидантными комплексами, содержащимися в активных компонентах формулы СИМїОНИЯ №1 и удлинением теломер путём активации выделения фермента теломераза молекулой Циклоастрагенола. Это свойство имеет долгосрочный накопительный эффект, который нельзя ощутить в моменте но уже доказанно многочисленными результатами анализов наших постоянных клиентов, в том числе опубликованных на нашем сайте!
Просто с годами Вы будете выглядеть и чувствовать себя моложе своих лет!
СИМїОНИЯ №1 улучшает качество жизни!

Основано на изобретении, получившем Нобелевскую Премию по физиологии и медицине за 2009 год

Победить процессы старения – давняя мечта человечества, над осуществлением которой работают ведущие ученые всего мира. Каждое новое открытие, связанное с тонкостями работы человеческого организма еще на шаг приближает нас к продлению жизни и улучшению ее качества.
В 2009 году трое американских учёных (Элизабет Блэкберн, Кэрол Грейдер и Джек Шостак) получили Нобелевскую премию за открытие механизма клеточного старения. Наши клетки постоянно делятся. Таким образом обновляются ткани. Однако, процесс деления не бесконечен, а в среднем составляет 50–60 раз. Каждый раз при делении Теломеры, находящиеся на концах клеточных хромосом, уменьшаются в длине. При достижении критической длины Теломер запускается процесс самоуничтожения организма: мы стареем, болеем возрастными заболеваниями и умираем.
Фермент теломераза позволяет Теломерам увеличиваться либо же оставаться на своем постоянном уровне. Таким образом, активируя работу фермента теломеразы жизнь клетки увеличивается, соответственно процесс старения организма замедляется.
Что входит в состав?

Экстракт Астрагала
Экстракт астрагала благодаря своему чудотворному составу обладает ярко выраженным антивозрастным эффектом. Растение идеально подходит для людей, которые стремятся замедлить процессы старения организма и долго оставаться в отличной физической форме. Помогает поддерживать ощущение активности и бодрости. Увеличивает выносливость, а вслучае переутомления возвращает энергию. Нормализует гормональные процессы, восстанавливает репродуктивную функцию.

Экстракт Шлемника
Шлемник поистине считается целебным растением и давно используется как в народной, так и в официальной медицине. Растение, благодаря своим полезным свойствам, способно повышать иммунную систему человека. Оказывает успокаивающее, ранозаживляющее действие. Также шлемник понижает уровень холестерина в крови, оптимизирует работу кишечника и желудка, устраняет запоры. Экстракт травы улучшает качество кожи т.к. ускоряет процесс обновления клеток, стимулирует образование коллагена и эластина.

Экстракт Имбиря
Имбирь известен в первую очередь тем, что способен прекрасно укреплять иммунитет и повышать общий тонус организма. Улучшает работу пищеварительной системы, нормализует метаболизм, что в свою очередь помогает в борьбе с лишним весом. Мало кто знает, что это растение отлично борется с прыщами и угревой сыпью, очищая кожу от недугов. Помогает справляться со стрессами, укрепляет нервную систему.

Экстракт Лимонника
Родиной Лимонника является Китай. Данное растение имеет многовековой опыт использования т.к. имеет обширный спектр позитивного воздействия на человеческий организм. Укрепляет сердечную мышцу, нервную систему, улучшает работу головного мозга, восстанавливает клетки печени, очищая от токсинов. Отлично помогает органам дыхательных путей. В составе лимонника присутствует йод, калий и селен. Борется с морщинами и дряблостью дермы, омолаживая кожу.

Гранатовый сок
Гранатовый сок активно используется при правильном питании. В его состав входят незаменимые аминокислоты, дубильные вещества, железо, калий, кальций, магний, витамины C, B6, B12, E, пектин, органические кислоты. В напитке кроется не только очевидная польза для иммунитета, но и прекрасный косметический эффект. Очищает сосуды, ускоряет обмен веществ, очищает организм от шлаков и токсинов.
Компоненты комплекса СИМїОНИЯ №1 являются биорегуляторами следующих процессов
Позаботьтесь о себе и своих близких!
Почувствуйте Превосходство!

Мы ориентированы на современную модель здравоохранения, базисом которой является использование результатов инноваций в науке и исследований для продления периода здоровой жизнедеятельности человека. Наша корпоративная культура основана на ценностях, формирующих принципиально новый образ и стиль жизни и открывающих персонально для Вас дверь в счастливое и активное долголетие. СИМїОНИЯ №1 - Ваш персональный омолаживающий комплекс, естественное долголетие и активность.
Мы не можем остановить ход времени, однако результаты анализов на степень клеточного старения организма наших постоянных покупателей показывают не только остановку старения, но даже значительное омоложение!
Закажите СИМїОНИЯ №1 прямо сейчас!




